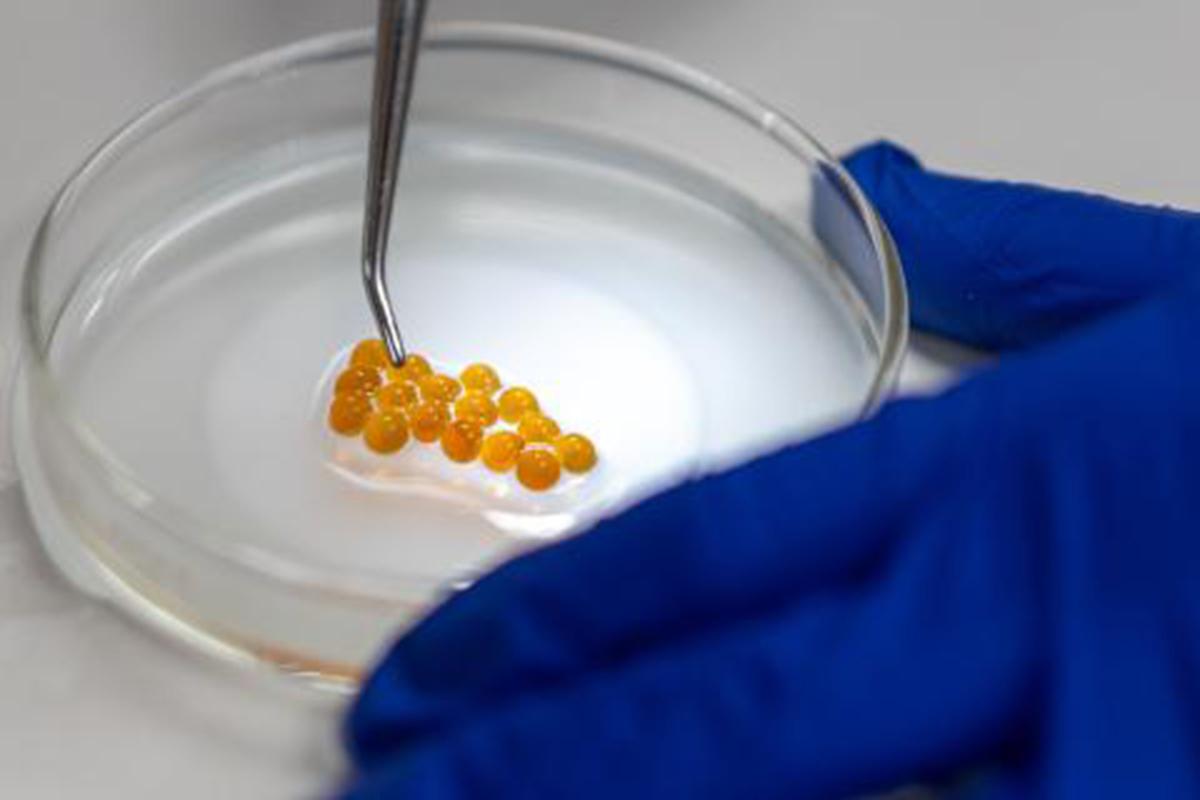
Rainbow trout eggs from the Ontario Aquaculture Research Centre in Alma

ACS - Archived Newsletters
Welcome to our Animal Care Community Newsletter. In each bi-monthly issue you will find updates from Animal Care Services, the Animal Care Committee, and stories from within our community. Our mission is to foster communication amongst those of us who use and work with animals in science at our institution. If you have any questions about the content of this newsletter or wish to contribute to our community spotlight please contact us at acc@uoguelph.ca.
Issue 8 - January 2026

Celebrating 102 years of College Royal
Gather your family, round up your friends, and get ready for the Annual College Royal Open House Weekend at the University of Guelph! This year, they're turning up the excitement and fun with their theme College Royal Rodeo, celebrating 102 years of tradition, community, and unforgettable fun.
Step into action with the free barn tours, livestock shows, dance and dog competition, art show, club displays, and more. Enjoy delicious food, hands-on activities, and tons of fun across campus. Whether you’re a first-time visitor or a lifelong College Royal fan, there is something for everyone to enjoy.
Issue 7 - November 2025

Implementing SOP.ACC.818 Asepsis for Rodent Survival Surgery
The Animal Care Committee invites all research personnel and facility staff to attend an upcoming Lunch & Learn focused on the implementation of SOP.ACC.818 – Asepsis for Rodent Survival Surgery.
The session, led by ACS veterinarians, will start with an overview of the SOP, followed by an opportunity for attendees to ask questions, and share experiences. Several research groups have identified challenges in meeting the updated requirements, and this session is intended to support implementation by researchers.
Issue 6 - September 2025
Scientific Merit Review: Administration Moving to Animal Care Services
Independent peer review of the scientific merit of animal-based research programs or projects, is an important part of the Animal Utilization Protocol (AUP) review process. The Canadian Council on Animal Care (CCAC) takes the position that “animal use in research must only be undertaken if expert, independent option has attested to the probable scientific value of the research within its field. Animal based- work can then proceed only if an institutional Animal Care Committee (ACC) finds the use of animals acceptable ethically…” (CCAC, 2013).
Issue 5 - July 2025

Animal Care Services Staff Updates
In this issue, we share updates from the CCAC National Workshop and CALAS Symposium, highlight new and ongoing training opportunities, and outline upcoming changes to the Animal Use Protocol process. We also provide staffing updates within ACS, including leadership transitions and temporary coverage. As always, we encourage researchers to make use of the support resources available and thank you for your continued cooperation.
Issue 4 - March 2025

Happy New Year from Animal Care Services
Plans to implement and transition to a new AUP system have been unexpectedly and indefinitely halted. Many of you contributed to this initiative through the advisory committee, which included representatives from across the research community. The process had progressed significantly — the RFP was completed, system demos were held, and two vendors had been shortlisted. However, we were informed that the procurement of a new system has been stopped due to budget constraints.
Issue 3 - January 2025

Happy New Year from Animal Care Services
With the first newsletter of the new year, we want to take a moment to thank our research and animal care community for your unwavering dedication and hard work. The care and attention you give to the animals is deeply appreciated and plays a vital role in fostering a culture of compassion at UofG. We look forward to continued collaboration in 2025, supporting your animal-based research while enhancing the well-being of the animals you work with.
Issue 2 - December 2024

Share and Subscribe
We thank our community for reading and sharing the first issue of the Animal Care Community Newsletter. We ask all investigators, educators, and facility managers to continue to share the newsletter with their staff and students. Those who wish to subscribe to the newsletter can submit their names to acc@uoguelph.ca and we will add them to the list.
Issue 1 - October 2024

Welcome
Welcome to the first edition of our Animal Care Community Newsletter. In each bi-monthly issue you will find updates from Animal Care Services, the Animal Care Committee, and stories from within our community. Our mission is to foster communication amongst those of us who use and work with animals in science at our institution. If you have any questions about the content of this newsletter or wish to contribute to our community spotlight please contact us at acc@uoguelph.ca.
